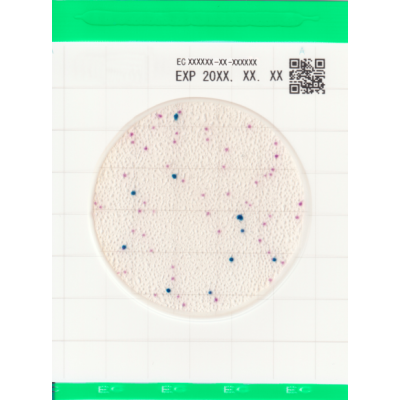
Easy Plate EC - Placi Teste Rapide pentru Detectia Staphylococcus Aureus

Easy Plate EC - Placi Teste Rapide pentru Detectia Staphylococcus Aureus
Transport Gratuit
Pentru comenzi peste 500 lei
Calitatea produselor garantata
Un nivel ridicat de calitate va determina o satisfacție mai deplină a clientului
Easy Plate AC reprezinta solutia moderna pentru detectarea rapida si precisa a Escherichia coli si bacteriilor coliforme in produse alimentare si probe de mediu. Certificat AOAC PTM si validat de NordVal si MicroVal, acest sistem de testare microbiologica ofera rezultate fiabile in doar 24 de ore, cu operare simpla si fara echipament suplimentar. Reduceti costurile de laborator si optimizati spatiul de lucru cu tehnologia autodifuzanta inovatoare.
Certificari si Standarde Internationale:
- Certificat AOAC PTM - recunoscut la nivel mondial
- Validat NordVal si MicroVal pentru precizie maxima
Design Inovator si Functionalitate:
- Folie impermeabila cu mediu uscat preparat
- Capac transparent pentru monitorizare usoara
- Autodifuzant - proba se raspandeste automat pe supfata
- Nu necesita echipament specializat de laborator
- Gata de utilizare - fara preparare prealabila
- Protocol simplu in 3 pasi: extragere proba, pipetare, incubare
Metoda Easy Plate EC a primit certificarea AOAC Research
Institute Performance Tested MethodsSM (031601) pentru carne de vita cruda,
carne de porc cruda, carne de porc cruda congelata, carne de miel cruda, somon
crud, cârnati si sunca gatita.
Specificatii Tehnice
| Produs | Easy Plate® EC |
| Producator | Easy Plate |
| Microorganisme tinta | Escherichia coli, baterii coliforme |
| Aplicatie | Testare probe carne, somon crud |
| Timp de incubare | 24 ore |
| Temperatura de incubare | 35 grade |
| Depozitare | 2-8 °C |
| Certificari | AOAC-PTM NordVal MicroVal |
| Continut pachet | 100 placi |
Set de produse